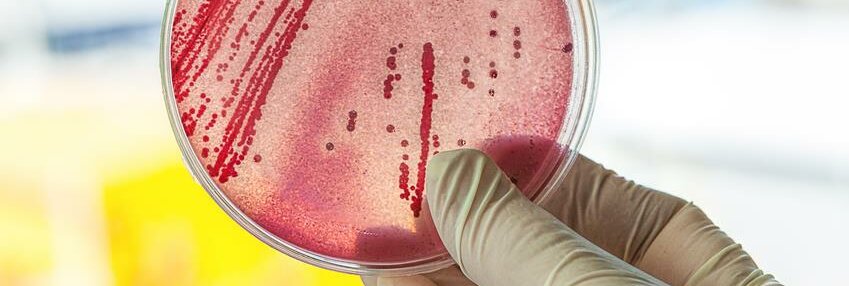

Antibiotikaresistenzen | Europäischer Antibiotikatag
GUTE TRENDS, SCHLECHTE TRENDS
Seite 1/1 2 Minuten
Eine europäische Vergleichsstudie, zu der auch das Robert Koch-Institut Daten beigetragen hat, zeigt, dass die Situation bei Antibiotikaresistenzen in Deutschland noch vergleichsweise weniger angespannt ist als in vielen anderen europäischen Staaten. „Dennoch gibt es auch in Deutschland deutlichen Verbesserungsbedarf und neben positiven Entwicklungen auch problematische Trends, die unbedingt gestoppt werden müssen“, betont Lothar H. Wieler, Präsident des Robert Koch-Instituts, anlässlich des Europäischen Antibiotikatags am 18. November.
Das „European Antimicrobial Resistance Surveillance Network“ erhebt Resistenzdaten für ausgewählte Erreger aus Blutkulturen als Grundlage für die Darstellung von zeitlichen Entwicklungen sowie von Unterschieden zwischen den Mitgliedsstaaten. Jährlich zum Europäischen Antibiotikatag wird ein Bericht mit den aktuellen Daten und Trends im zurückliegenden Vierjahres-Zeitraum veröffentlicht.
Der Anteil Methicilllin-resistenter Staphylococcus aureus , einer der wichtigsten Erregern von Krankenhausinfektionen, ist in Deutschland weiterhin rückläufig und liegt mit 11,8 Prozent unter dem europäischen Mittelwert, der bei ca. 18 Prozent stagniert. Im Zentrum der Aufmerksamkeit stehen seit einigen Jahren die Gram-negativen Erregern. Dazu gehören unter anderem Escherichia coli, die z.B. Harnwegsinfektionen verursachen, und Klebsiella pneumoniae, die im Krankenhaus zu Lungenentzündung und zu Sepsis (Blutvergiftung) führen können. Bei E. coli zum Beispiel ist die Resistenz gegenüber Cephalosporinen der 3. Generation – eine wichtige Gruppe von breit wirksamen Antibiotika – in Deutschland bereits auf über 10 Prozent gestiegen.
Eine wichtige Voraussetzung für gezielte Gegenmaßnahmen sind regelmäßig erhobene Daten zu Antibiotikaresistenzen und Antibiotikaverbrauch. Das Robert Koch-Institut erfasst daher bei der „Antibiotika-Resistenz-Surveillance“ (ARS), deren Ergebnisse auch im Internet abrufbar sind, in standardisierter Form Resistenzdaten aus mikrobiologischen Laboratorien. Auch ein ergänzendes Antibiotikaverbrauchs-System (AVS) ist gerade eingerichtet worden.
Die Bekämpfung von Antibiotikaresistenzen erfordert umfangreiche Anstrengungen und Zusammenarbeit in allen Bereichen. Das Bundesministerium für Gesundheit hat daher, fachlich auch vom RKI unterstützt, mit den Bundesministerien für Ernährung und Landwirtschaft sowie für Bildung und Forschung 2008 die Deutsche Antibiotika-Resistenz-Strategie (DART) entwickelt, an der auch die Bundesländer und weitere Akteure des Gesundheitswesens beteiligt sind. DART ist zuletzt 2015 aktualisiert worden.
Antibiotikaresistenzen sind ein natürlicher Teil der Umwelt. Sie entwickeln sich im Wechselspiel von genetischen Ereignissen – Mutationen oder die Aufnahme von Resistenzgenen aus der Umgebung – und Selektion. Selektion bedeutet, dass bei der Anwendung von Antibiotika solche Bakterienstämme überleben, die eine Resistenz besitzen. Entscheidend ist daher der Selektionsdruck durch den Einsatz von Antibiotika. Ein wichtiger Ansatz, Resistenzen zu vermindern, ist daher ihr gezielter Einsatz. So helfen Antibiotika zum Beispiel nicht gegen Erkältung oder Grippe. Resistenzgene können sich bei Gram-negativen Bakterien besonders leicht zwischen verschiedenen Bakterien(-arten) austauschen. „Resistenzen und Infektionskrankheiten müssen nachhaltig bekämpft werden. Daher sollten Mensch, Tier und Umwelt im Sinne des One-Health-Ansatzes in die Betrachtung einbezogen werden“, unterstreicht Lothar H. Wieler.
Resistente Erreger und Resistenzgene machen nicht an Ländergrenzen halt. Deshalb sind internationale Kooperationen und Maßnahmen in allen Ländern unbedingt notwendig. So spielen zum Beispiel bei Darmbakterien, die sogenannte Extended Spectrum Beta-Lactamasen (ESBL) bilden und damit eine wichtige Gruppe von Antibiotika unwirksam machen, Auslandsreisen eine Rolle. Studien zeigten, dass bis zu 30 Prozent der Reiserückkehrer aus Regionen mit hoher ESBL-Verbreitung (z.B. Asien und indischer Subkontinent) mit ESBL-bildenden E. coli kolonisiert sind. Die internationalen Herausforderungen sind auch Thema einer Tagung der Ostsee-Anrainerstaaten am 19.11.2015 in Berlin.
Quelle: Informationsdienst Wissenschaft (idw-online)